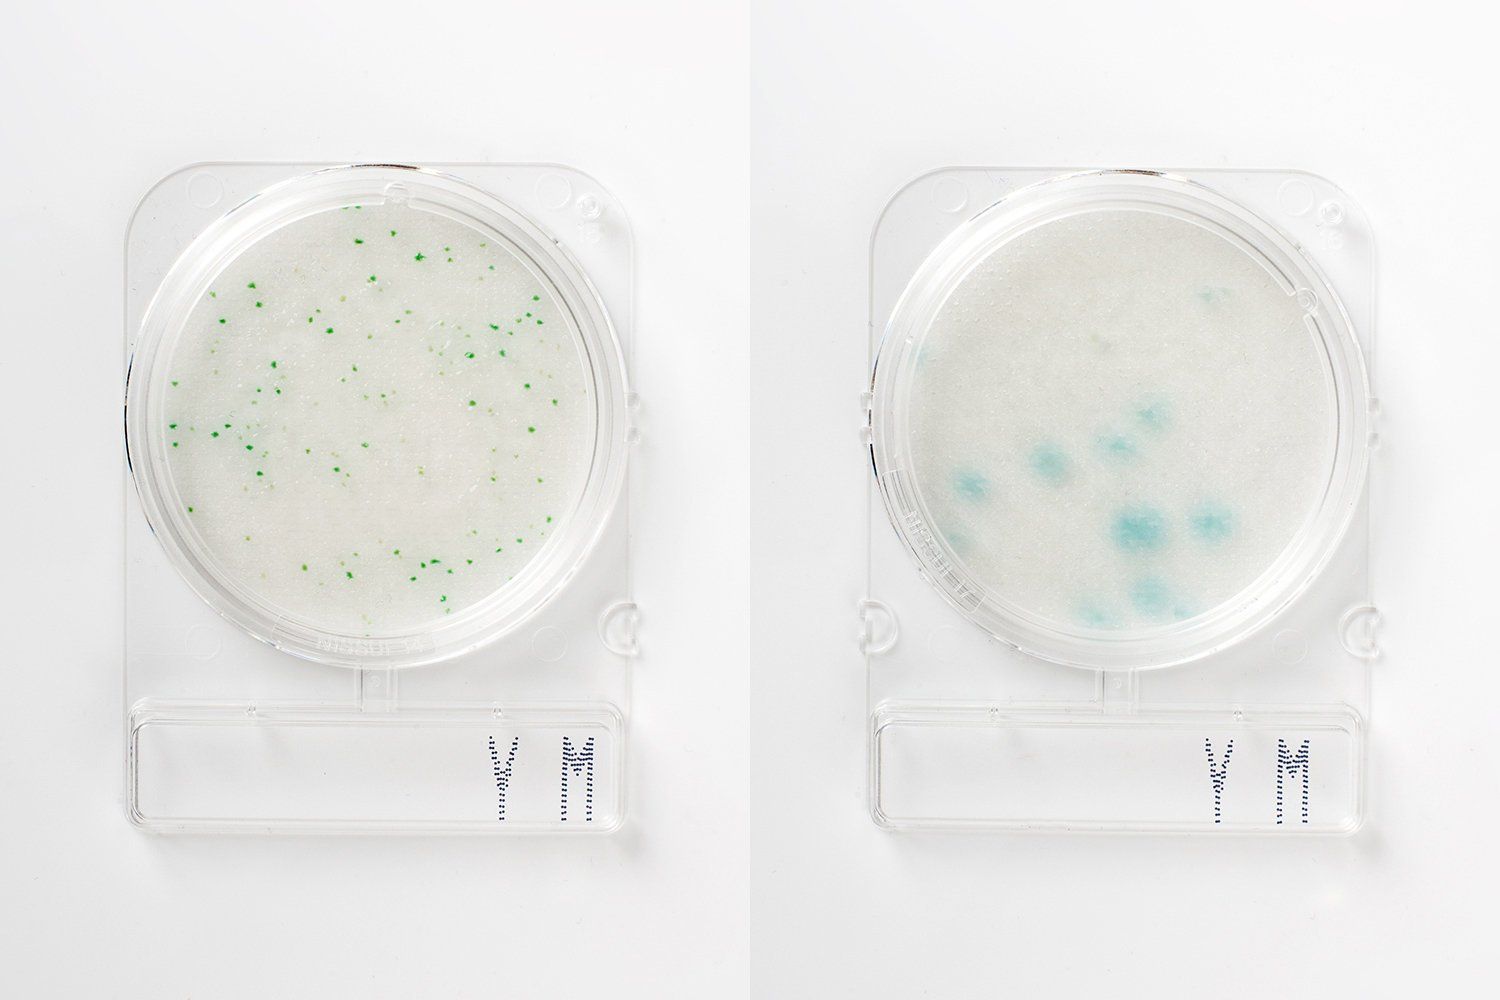

To Get More Information
Don't Hesitate to Contact Us
Company Address
Rukan Kirana Boutique Office
Blok F3 no 12, Boulevard Raya No.1 Kelapa Gading. Jakarta Utara
Indonesia, 14240
Contact
+6221 4585 8833
info@arasains.co.id
Quick Link
Product Link
Copyright (c) 2021 PT Arasains. All Right Reserved